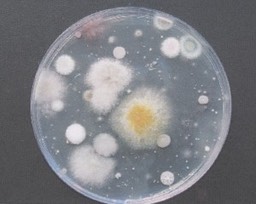
2a brudna myszka

Wchodząc w reakcję ze złuszczającym się naskórkiem z rąk i wydychanym przez człowieka powietrzem tworzą powstanie konidiów grzybów. Te tworzą substancje organiczne, które powtórnie wdycha człowieka. Powstałe w wyniku tego środowisko jest zagrożeniem dla zdrowia i jest przyczyną powstania wielu chorób.
W wyniku przeprowadzonych badań przez Instytut Przemysłu Cukrowniczego na nasze zlecenie okazało się, że powierzchnia sprzętu IT jest w dużym stopniu zanieczyszczona mikrobiologicznie przez bakterie mezofilne i pleśnie. Konieczne jest mycie i dezynfekcja sprzętu. W przeprowadzonych badaniach skuteczność tych zabiegów wyniosła od 92% do 100%.
Co więcej, w pomieszczeniach biurowych namnażające się plesnie ulegają rozwojowi tworząc źródło czynników alergennych dla użytkowników sprzętu komputerowego.
Poniżej przedstawiamy zdjęcia z przeprowadzonych badań na obecność mikrobiologicznego zanieczyszczenia ( bakterii, pleśni, grzybów i wirusów) na urządzeniach.